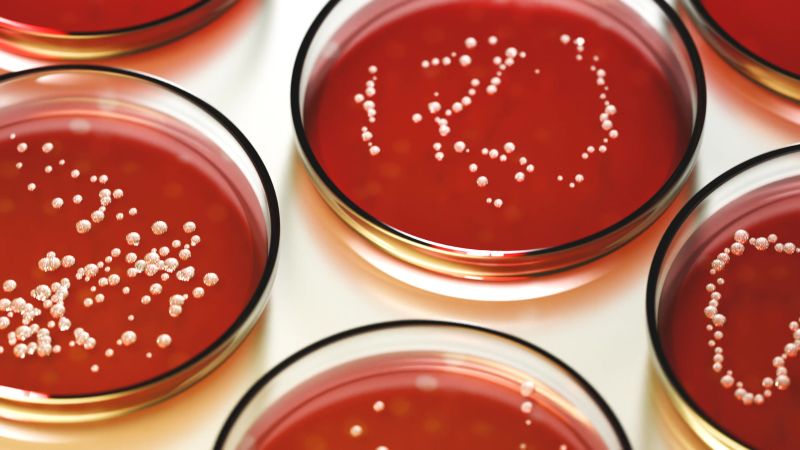
오명사마이신 A 생산을 4배 높인 스트렙토마이세스 변이 균주 개발 썸네일

기술이전 상세 정보를 불러오는 중입니다...

재조합 미생물 이용 카나마이신 계열 신규 항생물질 개발
기술분야
판매 유형
판매 상태
거래방식
기술 개요
기존 항생제에 대한 내성균 출현 및 카나마이신 생합성 경로의 복잡성으로 신규 항생제 개발에 어려움이 있었습니다. 본 기술은 *Streptomyces venezuelae*를 이종 숙주로 활용하여 카나마이신 생합성 유전자군(kanA-kanB-kanK 등)을 성공적으로 재조합하고, 이를 통해 카나마이신 항생물질의 생합성 경로를 명확히 규명했습니다. 이 재조합 미생물은 기존의 반합성 방식이 아닌 직접 발효를 통해 아미카신, 토브라마이신 등 다양한 카나마이신 유도체는 물론, 신규 화합물인 1-N-AHBA-카나마이신 X를 효율적으로 생산합니다. 특히 이 신규 화합물은 아미카신 내성균에 강력한 항균 효과를 보이며, 항바이러스 및 유전병 치료제로의 확장 가능성을 제시합니다. 본 기술은 항생제 내성 문제 해결과 경제적인 의약품 생산에 기여할 수 있습니다.
기본 정보
| 기술명 | 새로운 카나마이신 화합물, 카나마이신 생산 스트렙토마이세스 속 미생물 및 카나마이신의 생산 방법 | ||
| 기관명 | 이화여자대학교 산학협력단 | ||